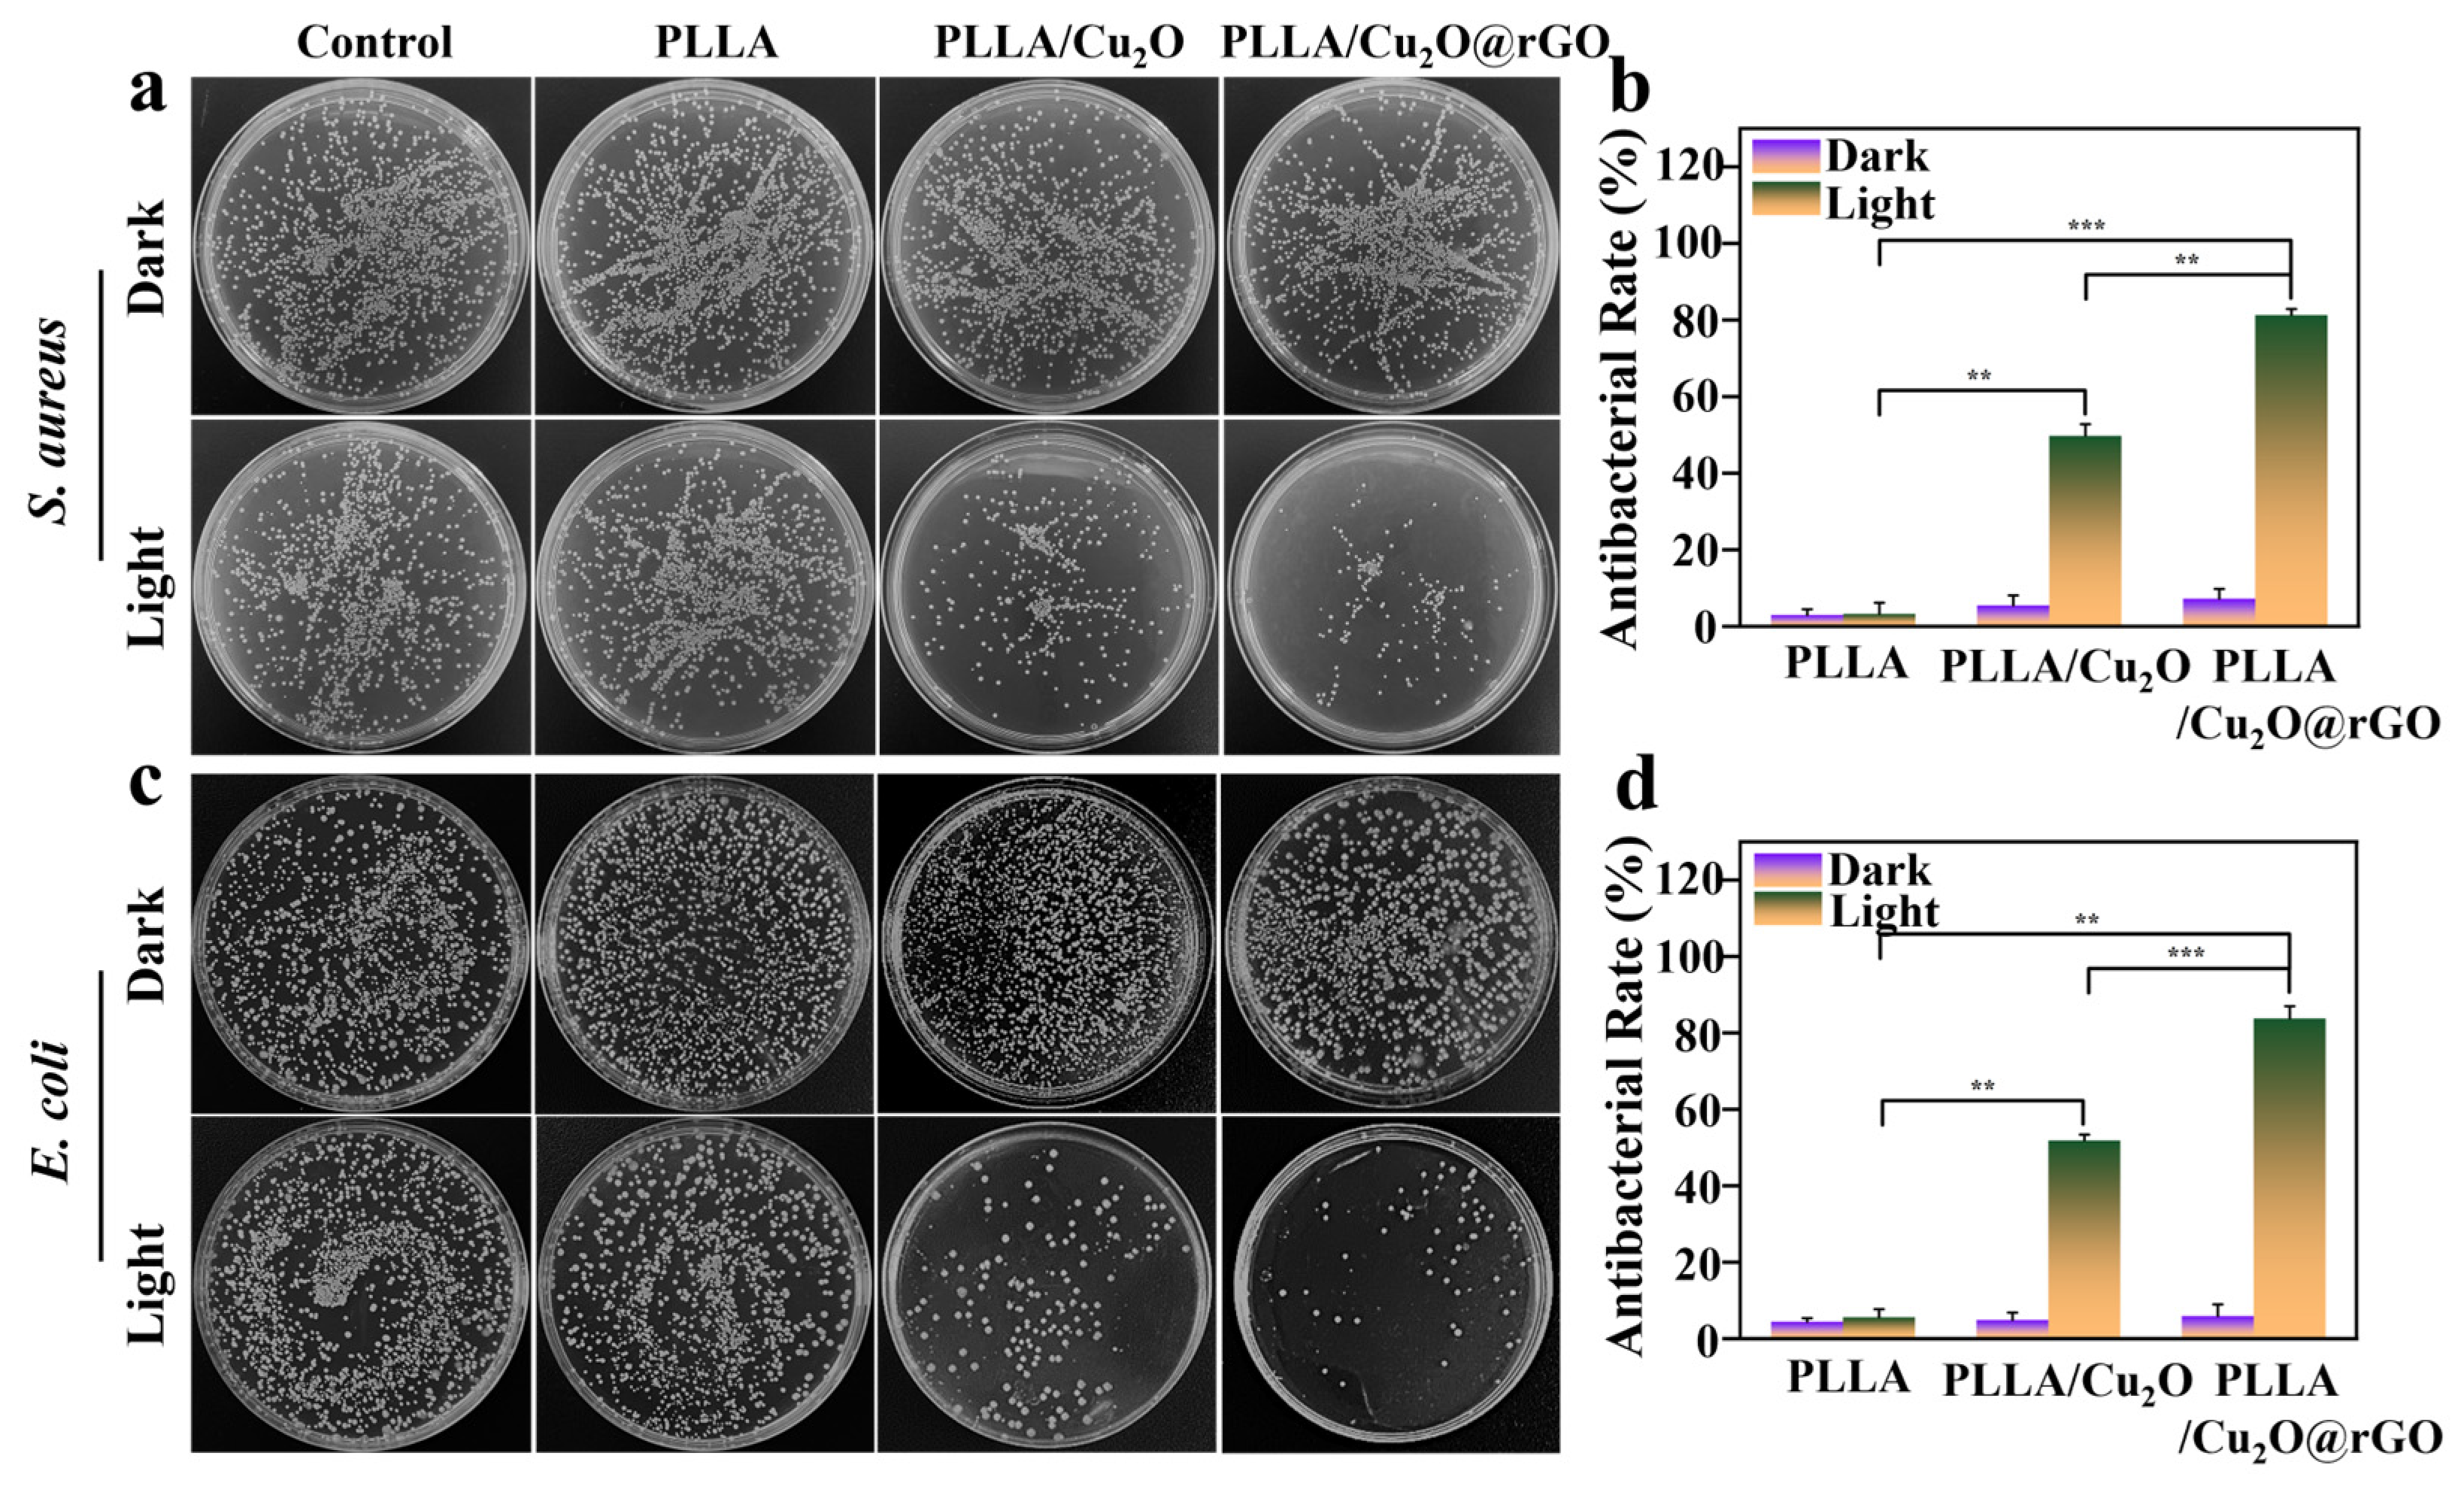
Nanomaterials 14 00452 g005

A Photochemically Active Cu2O Nanoparticle Endows Scaffolds with Good Antibacterial Performance by Efficiently Generating Reactive Oxygen Species
Abstract
1. Introduction
2. Materials and Methods
2.1. Material Source
2.2. Preparation of Cu2O and Cu2O@rGO
2.3. Scaffold Fabrication
2.4. Characterization of Nanoparticles
2.5. Antibacterial Experiment
2.6. ROS Detection
2.7. Protein Leakage Assessment
2.8. Cell Behavior
2.9. Statistical Analysis
3. Results and Discussion
3.1. Microstructure of the Synthesized Nanoparticles
3.2. Photodynamic Performance of Cu2O@rGO
3.3. In Vitro ROS Detection
3.4. Antibacterial Activity of the Scaffold
3.5. Antibacterial Mechanism of the Scaffold
3.6. Cellular Activity
4. Conclusions
Author Contributions
Funding
Data Availability Statement
Conflicts of Interest
References
- Hu, Y.; Li, S.; Dong, H.; Weng, L.; Yuwen, L.; Xie, Y.; Yang, J.; Shao, J.; Song, X.; Yang, D.; et al. Environment-Responsive Therapeutic Platforms for the Treatment of Implant Infection. Adv. Healthc. Mater. 2023, 12, 2300985. [Google Scholar] [CrossRef] [PubMed]
- Shuai, C.; Xie, J.; Jiang, X.; Peng, S.; Wang, C.J.V. Additively manufactured high entropy alloy with high wear resistance for biomedical implant. Vacuum 2023, 221, 112939. [Google Scholar] [CrossRef]
- Heydariyan, Z.; Soofivand, F.; Dawi, E.A.; Abd Al-Kahdum, S.A.; Hameed, N.M.; Salavati-Niasari, M. Technology, A comprehensive review: Different approaches for encountering of bacterial infection of dental implants and improving their properties. J. Drug Deliv. Sci. Technol. 2023, 84, 104401. [Google Scholar] [CrossRef]
- Pascale, R.; Toschi, A.; Aslan, A.T.; Massaro, G.; Maccaro, A.; Fabbricatore, D.; Dell’Aquila, A.; Ripa, M.; Işık, M.E.; Kızmaz, Y. Risk factors for Gram-negative bacterial infection of cardiovascular implantable electronic devices: Multicentre observational study (CarDINe Study). Int. J. Antimicrob. Agents 2023, 61, 106734. [Google Scholar] [CrossRef]
- Aghamohammad, S.; Rohani, M.J. Antibiotic resistance and the alternatives to conventional antibiotics: The role of probiotics and microbiota in combating antimicrobial resistance. Microbiol. Res. 2023, 267, 127275. [Google Scholar] [CrossRef]
- Ma, K.; Li, J.; Ma, H.; Yang, Y.; Yang, H.; Lu, J.; Li, Y.; Dou, J.; Wang, S.; Liu, S.J. 2D Cd-MOF and its mixed-matrix membranes for luminescence sensing antibiotics in various aqueous systems and visible fingerprint identifying. Chin. Chem. Lett. 2023, 34, 108227. [Google Scholar] [CrossRef]
- Shuai, C.; Wang, K.; Peng, S.; Zan, J.; Xiao, J.; Hu, S.; Zhong, Q. Interfaces, Accelerating Ce3+/Ce4+ Conversion in CeO2 via Mn doping to Endow Scaffolds with Chemodynamic Therapy Properties. Surf. Interfaces 2024, 45, 103846. [Google Scholar] [CrossRef]
- D’Souza, A.; Marshall, L.R.; Yoon, J.; Kulesha, A.; Edirisinghe, D.I.; Chandrasekaran, S.; Rathee, P.; Prabhakar, R.; Makhlynets, O.V. Peptide hydrogel with self-healing and redox-responsive properties. Nano Converg. 2022, 9, 18. [Google Scholar] [CrossRef]
- Pereira, D.; Ferreira, S.; Ramírez-Rodríguez, G.B.; Alves, N.; Sousa, Â.; Valente, J.F. Silver and Antimicrobial Polymer Nanocomplexes to Enhance Biocidal Effects. Int. J. Mol. Sci. 2024, 25, 1256. [Google Scholar] [CrossRef] [PubMed]
- Zhan, Y.; Hu, H.; Yu, Y.; Chen, C.; Zhang, J.; Jarnda, K.V.; Ding, P. Therapeutic strategies for drug-resistant Pseudomonas aeruginosa: Metal and metal oxide nanoparticles. J. Biomed. Mater. Res. Part A 2024. [Google Scholar] [CrossRef]
- Goderecci, S.S.; Kaiser, E.; Yanakas, M.; Norris, Z.; Scaturro, J.; Oszust, R.; Medina, C.D.; Waechter, F.; Heon, M.; Krchnavek, R.R. Silver oxide coatings with high silver-ion elution rates and characterization of bactericidal activity. Molecules 2017, 22, 1487. [Google Scholar] [CrossRef]
- Barbosa, H.F.G.; Piva, H.L.; Matsuo, F.S.; de Lima, S.C.G.; de Souza, L.E.B.; Osako, M.K.; Tedesco, A.C. Hybrid lipid-biopolymer nanocarrier as a strategy for GBM photodynamic therapy (PDT). Int. J. Biol. Macromol. 2023, 242, 124647. [Google Scholar] [CrossRef]
- Lin, J.; Li, D.; Li, C.; Zhuang, Z.; Chu, C.; Ostrikov, K.K.; Thompson, E.W.; Liu, G.; Wang, P. A review on reactive oxygen species (ROS)-inducing nanoparticles activated by uni-or multi-modal dynamic treatment for oncotherapy. Nanoscale 2023, 15, 11813–11833. [Google Scholar] [CrossRef]
- Ghorbani, J.; Rahban, D.; Aghamiri, S.; Teymouri, A.; Bahador, A. Photosensitizers in antibacterial photodynamic therapy: An overview. Laser Ther. 2018, 27, 293–302. [Google Scholar] [CrossRef]
- Bhattacharya, D.; Mukhopadhyay, M.; Shivam, K.; Tripathy, S.; Patra, R.; Pramanik, A. Recent developments in photodynamic therapy and its application against multidrug resistant cancers. Biomed. Mater. 2023, 18, 062005. [Google Scholar] [CrossRef] [PubMed]
- Zhou, Z.; Ergene, C.; Lee, J.Y.; Shirley, D.J.; Carone, B.R.; Caputo, G.A.; Palermo, E.F. Sequence and dispersity are determinants of photodynamic antibacterial activity exerted by peptidomimetic oligo (thiophene) s. ACS Appl. Mater. Interfaces 2018, 11, 1896–1906. [Google Scholar] [CrossRef] [PubMed]
- Ghosh, S.; Bera, S.; Sardar, S.; Pal, S.; Camargo, F.V.; D’Andrea, C.; Cerullo, G. Interfaces, Role of Efficient Charge Transfer at the Interface between Mixed-Phase Copper-Cuprous Oxide and Conducting Polymer Nanostructures for Photocatalytic Water Splitting. ACS Appl. Mater. Interfaces 2023, 15, 18867–18877. [Google Scholar] [CrossRef]
- Xia, H.Y.; Li, B.Y.; Ye, Y.T.; Wang, S.B.; Chen, A.Z.; Kankala, R.K. Transition Metal Oxide-Decorated MXenes as Drugless Nanoarchitectonics for Enriched Nanocatalytic Chemodynamic Treatment. Adv. Healthc. Mater. 2024, 2303582. [Google Scholar] [CrossRef]
- Abdelfatah, M.; Darwesh, N.; Atta, H.; Beltagi, A.M.; Sun, B.; El-Shaer, A.; Ismail, W. Inverting electrodeposited nanostructured Cu2O thin films from n-type to p-type semiconductors and variation of their physical and photoelectrochemical properties for optoelectronic applications. Ceram. Int. 2023, 49, 30732–30743. [Google Scholar] [CrossRef]
- Wang, B.; Wu, L.; Sun, A.; Liu, T.; Sun, L.; Li, W. Preparation of Cu2O/g-C3N4 Heterojunction with Enhanced Photocatalytic Antibacterial Activity under Visible Light. New J. Chem. 2023, 47, 13797–13809. [Google Scholar] [CrossRef]
- Ahmed, A.; Singh, A.; Young, S.-J.; Gupta, V.; Singh, M.; Arya, S. Manufacturing, Synthesis techniques and advances in sensing applications of reduced graphene oxide (rGO) Composites: A review. Compos. Part A Appl. Sci. Manuf. 2023, 165, 107373. [Google Scholar] [CrossRef]
- Mondal, A.; Prabhakaran, A.; Gupta, S.; Subramanian, V.R. Boosting photocatalytic activity using reduced graphene oxide (RGO)/semiconductor nanocomposites: Issues and future scope. ACS Omega 2021, 6, 8734–8743. [Google Scholar] [CrossRef]
- Suresh, R.; Mangalaraja, R.; Mansilla, H.D.; Santander, P.; Yáñez, J. Reduced graphene oxide-based photocatalysis. Green Photocatal. 2020, 34, 145–166. [Google Scholar]
- Olumurewa, K.O.; Taleatu, B.; Owoeye, V.A.; Fasakin, O.; Eleruja, M. Effect of incorporating graphene oxide in ZnS and study of the thermistor applications of ZnS-RGO film. Appl. Surf. Sci. Adv. 2023, 13, 100370. [Google Scholar] [CrossRef]
- Heo, J.; Bae, H.; Mane, P.; Burungale, V.; Seong, C.; Ha, J. Surface Engineering of Cu2O Photocathodes via Facile Graphene Oxide Decoration for Improved Photoelectrochemical Water Splitting. ACS Omega 2023, 8, 32794–32803. [Google Scholar] [CrossRef] [PubMed]
- Benhabbour, S.R.; Sheardown, H.; Adronov, A. Cell adhesion and proliferation on hydrophilic dendritically modified surfaces. Biomaterials 2008, 29, 4177–4186. [Google Scholar] [CrossRef] [PubMed]
- Ehtesabi, H.; Massah, F. Improvement of hydrophilicity and cell attachment of polycaprolactone scaffolds using green synthesized carbon dots. Mater. Today Sustain. 2021, 13, 100075. [Google Scholar] [CrossRef]
- Jang, J.; Choi, Y.; Tanaka, M.; Choi, J. Development of silver/graphene oxide nanocomposites for antibacterial and antibiofilm applications. J. Ind. Eng. Chem. 2020, 83, 46–52. [Google Scholar] [CrossRef]
- Jalil, S.A.; Akram, M.; Bhat, J.A.; Hayes, J.J.; Singh, S.C.; ElKabbash, M.; Guo, C. Creating superhydrophobic and antibacterial surfaces on gold by femtosecond laser pulses. Appl. Surf. Sci. 2020, 506, 144952. [Google Scholar] [CrossRef]
- Wang, K.; Lv, M.; Si, T.; Tang, X.; Wang, H.; Chen, Y.; Zhou, T. Mechanism analysis of surface structure-regulated Cu2O in photocatalytic antibacterial process. J. Hazard. Mater. 2024, 461, 132479. [Google Scholar] [CrossRef]
- Zhang, L.; Meng, Y.; Xie, B.; Ni, Z.; Xia, S. Br doping promotes the transform of Cu2O (100) to Cu2O (111) and facilitates efficient photocatalytic degradation of tetracycline. Mol. Catal. 2023, 548, 113431. [Google Scholar] [CrossRef]
- Feng, P.; Shen, S.; Yang, L.; Kong, Y.; Yang, S.; Shuai, C. Vertical and uniform growth of MoS2 nanosheets on GO nanosheets for efficient mechanical reinforcement in polymer scaffold. Virtual Phys. Prototyp. 2023, 18, e2115384. [Google Scholar] [CrossRef]
- Cleetus, A.; Teller, H.; Schechter, A. CuCr Bimetallic Catalyst for Selective Electrooxidation of Ammonia at Room Temperature. ChemCatChem 2023, 15, e202300035. [Google Scholar] [CrossRef]
- Smaisim, G.F.; Abed, A.M.; Al-Madhhachi, H.; Hadrawi, S.K.; Al-Khateeb HM, M.; Kianfar, E. Graphene-based important carbon structures and nanomaterials for energy storage applications as chemical capacitors and supercapacitor electrodes: A review. BioNanoScience 2023, 13, 219–248. [Google Scholar] [CrossRef]
- Sharif, A.; Farid, N.; Collins, A.; Jilani, A.; O’Connor, G.M. Extensive reduction of graphene oxide on thin polymer substrates by ultrafast laser for robust flexible sensor applications. Appl. Surf. Sci. 2023, 613, 156067. [Google Scholar] [CrossRef]
- Xie, F.; Zhao, S.; Bo, X.; Li, G.; Fei, J.; Ahmed, E.-A.M.; Zhang, Q.; Jin, H.; Wang, S.; Lin, Z. A robust solvothermal-driven solid-to-solid transition route from micron SnC2O4 to tartaric acid-capped nano-SnO2 anchored on graphene for superior lithium and sodium storage. J. Mater. Chem. A 2023, 11, 53–67. [Google Scholar] [CrossRef]
- Qi, F.; Li, H.; Gao, X.; Wang, Y.; Qian, H.; Li, W.; Liu, S.; Zhou, H.; Peng, S.; Shuai, C. Oxygen vacancy healing boosts the piezoelectricity of bone scaffolds. Biomater. Sci. 2024, 12, 495–506. [Google Scholar] [CrossRef]
- AlShammari, A.; Halim, M.; Yam, F.; Kaus, N.M. Synthesis of Titanium Dioxide (TiO2)/Reduced Graphene Oxide (rGO) thin film composite by spray pyrolysis technique and its physical properties. Mater. Sci. Semicond. Process. 2020, 116, 105140. [Google Scholar] [CrossRef]
- Guan, J.; Guo, Y.; Ma, G.; Zhang, L.; Fan, G.; Yu, H.; Han, N.; Chen, Y. Monolithic Cu2O-CuO/Cu Mesh Catalyst for Ambient Ozone Removal. ACS Appl. Eng. Mater. 2023, 1, 2782–2790. [Google Scholar] [CrossRef]
- Li, H.; Zhang, L.; Zhang, X.; Zhu, G.; Zheng, D.; Luo, S.; Wu, M.; Li, W.-H.; Liu, F.-Q. Interfaces, Self-Enhanced Antibacterial and Antifouling Behavior of Three-Dimensional Porous Cu2O Nanoparticles Functionalized by an Organic–Inorganic Hybrid Matrix. ACS Appl. Mater. Interfaces 2023, 15, 38808–38820. [Google Scholar] [CrossRef]
- Di, S.; Guo, S.; Wang, Y.; Wang, W.; Jung, Y.M.; Chen, L.; Wang, L. Physics, Surface plasmon resonance effect on charge transfer in Ag@ Cu2O-rGO composites. Mater. Chem. Phys. 2023, 301, 127621. [Google Scholar] [CrossRef]
- Zhou, Y.; Chen, G.; Yu, Y.; Hao, L.; Han, Z.; Yu, Q. Oxygen functional groups induced formation of Cu2O nanoparticles on the surface of reduced graphene oxide. New J. Chem. 2013, 37, 2845–2850. [Google Scholar] [CrossRef]
- Bahiraei, H.; Azarakhsh, S.; Ghasemi, S. Ternary CoFe2O4/g-C3N4/ZnO heterostructure as an efficient and magnetically separable visible-light photocatalyst: Characterization, dye purification, and mechanism. Ceram. Int. 2023, 49, 21050–21059. [Google Scholar] [CrossRef]
- Qu, C.; Wang, H.; Man, Y.; Li, Z.; Ma, P.; Chang, P.; Li, X.; Han, C.; Pang, Y.; Xu, H. Asymmetric intramolecular charge transfer enables highly efficient red thermally activated delayed fluorescent emitters. Chem. Eng. J. 2023, 457, 141061. [Google Scholar] [CrossRef]
- Feng, P.; Zhao, R.; Yang, F.; Peng, S.; Pan, H.; Shuai, C. Co-continuous structure enhanced magnetic responsive shape memory PLLA/TPU blend fabricated by 4D printing. Virtual Phys. Prototyp. 2024, 19, e2290186. [Google Scholar] [CrossRef]
- Liang, G.; Li, Z.; Ishaq, M.; Zheng, Z.; Su, Z.; Ma, H.; Zhang, X.; Fan, P.; Chen, S. Charge Separation Enhancement Enables Record Photocurrent Density in Cu2ZnSn (S, Se) 4 Photocathodes for Efficient Solar Hydrogen Production. Adv. Energy Mater. 2023, 13, 2300215. [Google Scholar] [CrossRef]
- Zambrzycki, M.; Piech, R.; Raga, S.R.; Lira-Cantu, M.; Fraczek-Szczypta, A. Hierarchical carbon nanofibers/carbon nanotubes/NiCo nanocomposites as novel highly effective counter electrode for dye-sensitized solar cells: A structure-electrocatalytic activity relationship study. Carbon 2023, 203, 97–110. [Google Scholar] [CrossRef]
- Boukhoubza, I.; Derkaoui, I.; Basyooni, M.A.; Achehboune, M.; Khenfouch, M.; Belaid, W.; Enculescu, M.; Matei, E. Physics, Reduced graphene oxide-functionalized zinc oxide nanorods as promising nanocomposites for white light emitting diodes and reliable UV photodetection devices. Mater. Chem. Phys. 2023, 306, 128063. [Google Scholar] [CrossRef]
- Lin, L.; Lin, P.; Song, J.; Zhang, Z.; Wang, X.; Su, W. Boosting the photocatalytic activity and stability of Cu2O for CO2 conversion by LaTiO2N. J. Colloid Interface Sci. 2023, 630, 352–362. [Google Scholar] [CrossRef]
- Miao, Y.-B.; Ren, H.-X.; Zhang, G.; Song, F.-X.; Liu, W.; Shi, Y. Achieving precise non-invasive ROS spatiotemporal manipulation for colon cancer immunotherapy. Chem. Eng. J. 2024, 481, 148520. [Google Scholar] [CrossRef]
- Gao, C.; Yao, X.; Deng, Y.; Pan, H.; Shuai, C. Laser-beam powder bed fusion followed by annealing with stress: A promising route for magnetostrictive improvement of polycrystalline Fe81Ga19 alloys. Addit. Manuf. 2023, 68, 103516. [Google Scholar] [CrossRef]
- Ling, C.; Li, Q.; Zhang, Z.; Yang, Y.; Zhou, W.; Chen, W.; Dong, Z.; Pan, C.; Shuai, C. Influence of heat treatment on microstructure, mechanical and corrosion behavior of WE43 alloy fabricated by laser-beam powder bed fusion. Int. J. Extrem. Manuf. 2023, 6, 015001. [Google Scholar] [CrossRef]
- Zhang, X.; Liew, K.J.; Chong, C.S.; Cai, X.; Chang, Z.; Jia, H.; Liu, P.; He, H.; Liu, W.; Li, Y. Low-Temperature Air Plasma Jet for Inactivation of Bacteria (S. aureus and E. coli) and Fungi (C. albicans and T. rubrum). Acta Phys. Pol. A 2023, 143, 12–18. [Google Scholar] [CrossRef]
- Liu, M.; Zuo, S.; Guo, X.; Peng, J.; Xing, Y.; Guo, Y.; Li, C.; Xing, H. The Study of Overexpression of Peroxiredoxin-2 Reduces MPP+-Induced Toxicity in the Cell Model of Parkinson’s Disease. Neurochem. Res. 2023, 48, 2129–2137. [Google Scholar] [CrossRef] [PubMed]
- Mito, K.; Lachnish, J.; Le, W.; Chan, C.; Chang, Y.-L.; Yao, J. Scaffold-Free Bone Marrow-Derived Mesenchymal Stem Cell Sheets Enhance Bone Formation in a Weight-Bearing Rat Critical Bone Defect Model. Tissue Eng. Part A 2023, 30, 107–114. [Google Scholar] [CrossRef] [PubMed]
- Liu, Y.; Ming, L.; Luo, H.; Liu, W.; Zhang, Y.; Liu, H.; Jin, Y. Integration of a calcined bovine bone and BMSC-sheet 3D scaffold and the promotion of bone regeneration in large defects. Biomaterials 2013, 34, 9998–10006. [Google Scholar] [CrossRef]
- Zhang, X.; Zhang, H.; Zhang, Y.; Huangfu, H.; Yang, Y.; Qin, Q.; Zhang, Y.; Zhou, Y. 3D printed reduced graphene oxide-GelMA hybrid hydrogel scaffolds for potential neuralized bone regeneration. J. Mater. Chem. B 2023, 11, 1288–1301. [Google Scholar] [CrossRef] [PubMed]

Disclaimer/Publisher’s Note: The statements, opinions and data contained in all publications are solely those of the individual author(s) and contributor(s) and not of MDPI and/or the editor(s). MDPI and/or the editor(s) disclaim responsibility for any injury to people or property resulting from any ideas, methods, instructions or products referred to in the content. |
© 2024 by the authors. Licensee MDPI, Basel, Switzerland. This article is an open access article distributed under the terms and conditions of the Creative Commons Attribution (CC BY) license (https://creativecommons.org/licenses/by/4.0/).
Share and Cite
He, Y.; Zan, J.; He, Z.; Bai, X.; Shuai, C.; Pan, H. A Photochemically Active Cu2O Nanoparticle Endows Scaffolds with Good Antibacterial Performance by Efficiently Generating Reactive Oxygen Species. Nanomaterials 2024, 14, 452. https://doi.org/10.3390/nano14050452
He Y, Zan J, He Z, Bai X, Shuai C, Pan H. A Photochemically Active Cu2O Nanoparticle Endows Scaffolds with Good Antibacterial Performance by Efficiently Generating Reactive Oxygen Species. Nanomaterials. 2024; 14(5):452. https://doi.org/10.3390/nano14050452
Chicago/Turabian StyleHe, Yushan, Jun Zan, Zihui He, Xinna Bai, Cijun Shuai, and Hao Pan. 2024. "A Photochemically Active Cu2O Nanoparticle Endows Scaffolds with Good Antibacterial Performance by Efficiently Generating Reactive Oxygen Species" Nanomaterials 14, no. 5: 452. https://doi.org/10.3390/nano14050452
APA StyleHe, Y., Zan, J., He, Z., Bai, X., Shuai, C., & Pan, H. (2024). A Photochemically Active Cu2O Nanoparticle Endows Scaffolds with Good Antibacterial Performance by Efficiently Generating Reactive Oxygen Species. Nanomaterials, 14(5), 452. https://doi.org/10.3390/nano14050452
